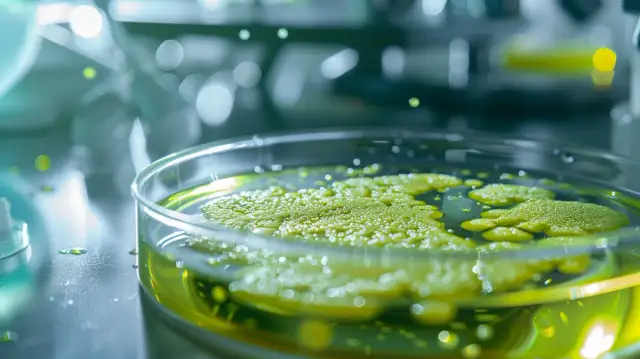
Clostridium difficile - groźne objawy zakażenia bakterią

Chroniczne zmęczenie - niepokojące objawy osłabienia
Czy zmagasz się z uporczywym uczuciem zmęczenia i osłabienia organizmu? Odkryj przyczyny chronicznego zmęczenia, objawy oraz sposoby na walkę z tym niepokojącym stanem

Czy zmagasz się z uporczywym uczuciem zmęczenia i osłabienia organizmu? Odkryj przyczyny chronicznego zmęczenia, objawy oraz sposoby na walkę z tym niepokojącym stanem

Odkryj przyczyny, objawy i skuteczne metody leczenia chorób immunosupresyjnych. Poznaj czynniki ryzyka i dowiedz się, jak chronić swój układ odpornościowy.

Poznaj kluczowe różnice między chorobami bakteryjnymi a wirusowymi, ich charakterystykę, objawy i metody leczenia. Dowiedz się, jak skutecznie zapobiegać tym zmaganiom zdrowotnym.
Clostridium difficile objawy to groźne infekcje jelitowe. Poznaj przyczyny i czynniki ryzyka zakażenia tą bakterią, charakterystyczne objawy oraz sposoby leczenia.

Dowiedz się wszystkiego o chorobach stawów – ich przyczynach, objawach i leczeniu. Przeczytaj o reumatoidalnym zapaleniu stawów, osteoartrozie, dnie moczanowej i innych chorobach stawów. Zapobiegaj problemom i utrzymuj zdrowie swoich stawów.

Odkryj, jakie produkty musisz bezwzględnie wyeliminować z diety przy celiakii czego nie jeść, aby uniknąć nieprzyjemnych objawów i komplikacji zdrowotnych

Czy zmagasz się z uporczywymi bólami brzucha, wzdęciami czy zaburzeniami wypróżnień? To mogą być niepokojące chore jelita objawy sygnalizujące poważniejszy problem. Dowiedz się o przyczynach i leczeniu tych dolegliwości.

Poznaj charakterystyczne candida objawy, takie jak zaczerwienienia skóry, naloty w jamie ustnej, bóle brzucha czy upławy. Sprawdź, jakie dolegliwości mogą sygnalizować zakażenie grzybicą candida.

Poznaj skuteczne sposoby leczenia zakażenia candida albicans. Dowiedz się, jak pozbyć się uciążliwych objawów grzybicy przy pomocy leków i naturalnych metod. Czy candida non albicans to również problem? Wszystko o przyczynach i czynnikach ryzyka.

Celiakia to choroba autoimmunologiczna wywołana nietolerancją glutenu. Poznaj charakterystyczne objawy celiakii, w tym dolegliwości żołądkowo-jelitowe, niedobory i kluczowe informacje o leczeniu

Odkryj przyczyny bólu brzucha i klatki piersiowej - od niegroźnych po zagrażające życiu. Dowiedz się, które objawy wymagają natychmiastowej pomocy medycznej. Poznaj skuteczne sposoby radzenia sobie z tymi dolegliwościami.

Poznaj przyczyny częstego bulgotania w brzuchu i nadmiernej ilości gazów. Nietolerancje pokarmowe, zaburzona flora bakteryjna czy schorzenia układu trawiennego - dowiedz się więcej.

Dowiedz się, co oznaczają bakterie w moczu d liczne - wynik sugerujący groźną infekcję układu moczowego. Poznaj przyczyny, objawy i sposoby leczenia.

Dowiedz się, jak leczyć bakteryjne zapalenie skóry i jelit za pomocą antybiotyków, ziół i zmian w diecie. Skuteczne metody przemywania ran i zapobiegania infekcjom.

Biegunka po antybiotyku czy probiotyku to częsty efekt uboczny tych preparatów. Poznaj przyczyny i sposoby na zminimalizowanie ryzyka biegunki po probiotyku oraz naturalną ulgę w tych dolegliwościach.

Zakażenia bakteryjne jelita grubego mogą powodować nieprzyjemne objawy, takie jak biegunka, skurcze brzucha i gorączka. Poznaj rodzaje bakterii w jelicie grubym, ich objawy, powikłania i sposoby leczenia.

Dowiedz się, na czym polega badanie żywej kropli krwi i dlaczego warto je wykonać. Ta nieinwazyjna metoda pozwala przyjrzeć się komórkom krwi pod mikroskopem i wykryć potencjalne niedobory oraz nieprawidłowości

Poznaj rodzaje groźnych bakterii układu pokarmowego, objawy infekcji, metody diagnozowania i leczenia chorób jelitowych oraz zapalenia spowodowane przez pasożyty.

Poznaj znaczenie badania rf i naucz się interpretować jego wyniki. Odkryj, co to jest badanie rf, jakie są prawidłowe wartości oraz przyczyny podwyższonych poziomów czynnika reumatoidalnego.

Poznaj objawy owsików u dzieci i przyczyny zakażenia. Dowiedz się, kiedy konieczne jest badanie na owsik i jak się do niego przygotować. Sprawdź domowe i profesjonalne metody leczenia.

Sprawdź cennik badania kału na pasożyty u dzieci i dowiedz się, jak przygotować się do badania, gdzie je wykonać oraz jak interpretować wyniki. Poznaj rodzaje wykrywanych pasożytów i wskazówki dla niemowląt.

Sprawdź, ile kosztuje badanie flory bakteryjnej jelit i czy możesz ubiegać się o refundację z NFZ. Poznaj dokładnie przygotowanie, objawy, czynniki wpływające na cenę tego ważnego testu.

Dowiedz się, na czym polega badanie mikrobioty jelitowej i jak należy się do niego odpowiednio przygotować. Odkryj metody analizy mikrobiomu, korzyści zdrowotne oraz interpretację wyników.

Dowiedz się, jakie badania na gluten i celiakię warto wykonać przy podejrzeniu nietolerancji. Sprawdź rodzaje testów krwi, przygotowanie do badań oraz możliwości bezpłatnej diagnostyki.

Poznaj przyczyny wykonywania badań na robaki u dzieci, typowe objawy robaczyccy oraz sposoby przygotowania dziecka do badania kału. Dowiedz się również, jakie badania na robaki są konieczne w różnych sytuacjach.

Odkryj wiarygodną wiedzę na temat diagnostyki zakażenia bakterią Helicobacter pylori – dowiedz się, jakie badania krwi i testy oddechowe należy wykonać oraz jak interpretować wyniki. Helicobacter pylori badanie nigdy nie było tak przystępnie wyjaśnione!

Dowiedz się, jakie badania są niezbędne do rozpoznania celiakii. Poznaj objawy nietolerancji glutenu oraz testy serologiczne i biopsję jelita cienkiego w diagnostyce celiakii.